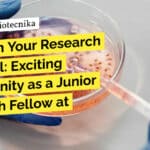
"Unleash Your Research Potential: Exciting Opportunity as a Junior Research Fellow at MAHE!"

Home Search
microbiology - search results
If you're not happy with the results, please do another search
TMC-ACTREC Ovarian Cancer Project JRF Job – Attend Walk-In-Interview
TMC-ACTREC Cancer Project JRF Job - Attend Walk-In-Interview
TATA MEMORIAL CENTRE
ADVANCED CENTRE FOR TREATMENT, RESEARCH
AND EDUCATION IN CANCER
Kharghar, Navi Mumbai- 410 210
www.actrec.gov.in
Phone...
CSIR-CFTRI Admission – PhD Under University of Mysore (August 2024)
CFTRI Admission 2024 August – PhD Under University of Mysore
CSIR-CFTRI Ph.D. ADMISSION (August 2024)
Ph.D. under University of Mysore
CSIR-CFTRI is a recognized organization for doing...
Govt IBSD Food Tech, Life Sciences, Biotech, Biochem Job With Rs. 47,000 pm Pay,...
Govt IBSD Food Tech, Life Sciences, Biotech, Biochem Job With Rs. 47,000 pm Pay, Apply Now
INSTITUTE OF BIORESOURCES & SUSTAINABLE DEVELOPMENT (IBSD) DEPARTMENT OF...
Biotecnika Times Newsletter 27.02.2024 – Govt Jobs, Top 20 Summer Internships/ Training/ Fellowships
Govt Botanical Survey of India BSc Life Science Project Recruitment – Attend Walk-In
Attend the walk-in for the Govt BSI Project Job suitable for BSc...
JRF Recruitment at MAHE Manipal For Biological Sciences, Apply Now
JRF Recruitment at MAHE Manipal For Biological Sciences, Apply Now
Manipal Academy of Higher Education (MAHE), Manipal, invites applications for the following positions for the...
Top 20 Summer Internships / Training / Fellowship in Biotech & Life Science 2024
Top 20 Biotech & Life Science Summer Internships / Training 2024
Get ready for an exciting summer of learning and discovery in the world of...
CSIR-CCMB Bioinformatics Project Scientist Job With Rs. 75,000 pm Pay – Attend Walk-In-Interview
CSIR-CCMB Bioinformatics Project Scientist Job With Rs. 75,000 pm Pay - Attend Walk-In-Interview
CSIR-CCMB Bioinformatics Project Scientist Job With Rs. 75,000 pm Pay - Attend...
Calcutta University Non-Medical Research Job With Rs. 56,000 pm Pay – Apply Now
Calcutta University Non-Medical Research Job With Rs. 56,000 pm Pay - Apply Now
Advertisement for Project Research Scientist-I (Non-medical) in Microbiology
Date: 12.02.2024
Applications are invited from...
ILS Bhubaneswar Biotech Research Job – Apply Online
ILS Bhubaneswar Biotech Research Job - Apply Online
INSTITUTE OF LIFE SCIENCES
(An Autonomous Institute under the Dept. of Biotechnology, Ministry of Science & Technology, Govt....
Salary of Rs. 40,000 pm Pay at AIIMS Delhi – Life Sciences Apply
AIIMS Research Jobs 2024 - Life Sciences Apply
ALL INDIA INSTITUTE OF MEDICAL SCIENCES
A newly sanctioned research project titled “Evaluation of Loop Mediated Isothermal Amplification...
Biotecnika Times Newsletter 22.02.2024 IIT Hyderabad SURE Internships 2024, Govt CMERTI, Multiple Internships +...
IIT Hyderabad Summer Undergraduate Research Exposure (SURE) Internships 2024, Apply Online
Apply online for the IIT Hyderabad SURE Internships 2024.
Govt CMERTI Project Assistant Job Openings...
Biotecnika Times Newsletter 21.02.2024 Govt PCIM&H, Delhi NCT Jobs, JNCASR POBE-2024 Admission, 15 NCBS...
Govt Ministry of AYUSH PCIM&H Microbiologist Recruitment – Apply Now
Apply now for the Government PCIMH Microbiologist Recruitment.
Govt Job With Rs. 56,000 pm Pay at...
MAHE Biotech Research Job – Earn Rs. 61,000 pm! Apply Now!
MAHE Biotech Research Job - Earn Rs. 61,000 pm! Apply Now!
Research Positions
Manipal Academy of Higher Education (MAHE), Manipal invites applications for the following positions...
Clarivate Associate Pharmacovigilance Specialist For Life Science, Apply Online
Clarivate Associate Pharmacovigilance Specialist For Life Science, Apply Online
Position: Associate Pharmacovigilance Specialist
Reports To: Director, Consulting; Senior Manager, Pharmacovigilance; Manager, Pharmacovigilance
Organization: Clarivate Analytics
Position Summary:
The Associate pharmacovigilance specialist performs...
Govt Ministry of AYUSH PCIM&H Microbiologist Recruitment – Apply Now
Govt PCIM&H Microbiologist Recruitment - Apply Now
F. No. PCIM&H/S. 26075/Manpower/2023-24/2152
Advertisement No. 01/2024
Engagement of Outsourced Manpower (through an outsourcing agency) in PCIM&H, Ghaziabad
In partial revision...